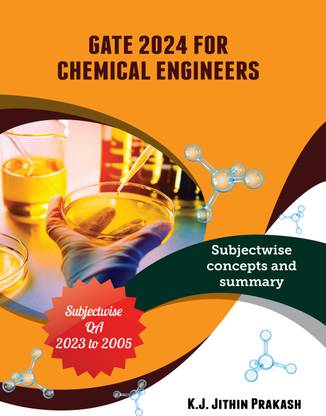
GATE Exam Collection for 2024 - Subjectwise Solved 18 Years of Question Papers and detailed Objective type Answers from 2005 till 2023, Chemical Engineering

GATE Exam Collection for 2024 - Subjectwise Solved 18 Years of Question Papers and detailed Objective type Answers from 2005 till 2023, Chemical Engineering (Paperback, K.J. Jithin Prakash)
Price: Not Available
Currently Unavailable
Highlights
- Binding: Paperback
- ISBN: 9788194228554
Be the first to ask about this product
Safe and Secure Payments.Easy returns.100% Authentic products.
Back to top




